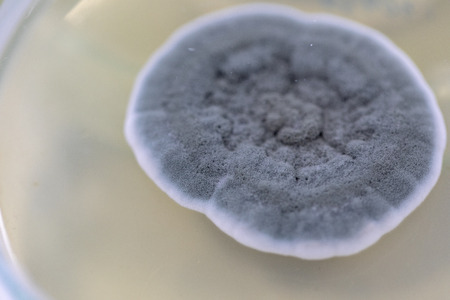

写真素材 - Penicillium, ascomycetous fungi are of major importance in the natural environment as well as food and drug production.Â
作品情報
Penicillium, ascomycetous fungi are of major importance in the natural environment as well as food and drug production.Â
- ID:117972764
- 作品種別:写真
- 作者名:sinhyu
キーワード
- allergy
- antibiotic
- ascomycetous
- background
- bacteria
- biology
- bioremediation
- cells
- colony
- conidiospores
- corrosion
- culture
- disease
- drug
- drugs
- environment
- food
- fungal
- fungi
- fungus
- health
- healthcare
- hygiene
- hyphae
- infectious
- isolated
- laboratory
- macro
- medicine
- microbes
- microbial
- microbiology
- mold
- mould
- mycelium
- mycology
- mycosis
- natural
- nature
- pencil-like
- penicillin
- penicillium
- plate
- rotting
- science
- scientific
- spore
- spores
- test
- white
類似作品
A single mushro...
Pleated inkcap ...
Close-up mushro...
Lactarius tormi...
Death Cap Amani...
Dangerous poiso...
Nature Brown mu...
Fresh organic f...
View of vibrant...
Small mushrooms...
Mushroom in the...
poisonous paras...
Generative AI :...
Bioluminescent ...
Amanita muscari...
Brown wind mush...
Fragile not eat...
Fresh fly agari...
A group of mush...
Closeup of port...
Single red toad...
Hypholoma fasci...
Mushrooms growi...
An intimate vie...
Mushroom Kingdo...
pink burn cup o...
Amanita Mairei ...
Close-up of lar...
orange mushroom...
Beautiful bolet...
Group of fungi ...
Macro photo of ...
mushroom
Beautiful wild ...
a cluster of ti...
Champagne Mushr...
3d illustration...
Mushroom in the...
Snail shell on ...
Mushrooms in th...
chestnut brittl...
Small yellow mu...
Nature Brown mu...
a group of mush...
Closeup small m...
Mushrooms in th...
Wild mushrooms,...
Abstract imge o...
fly agaric (toa...